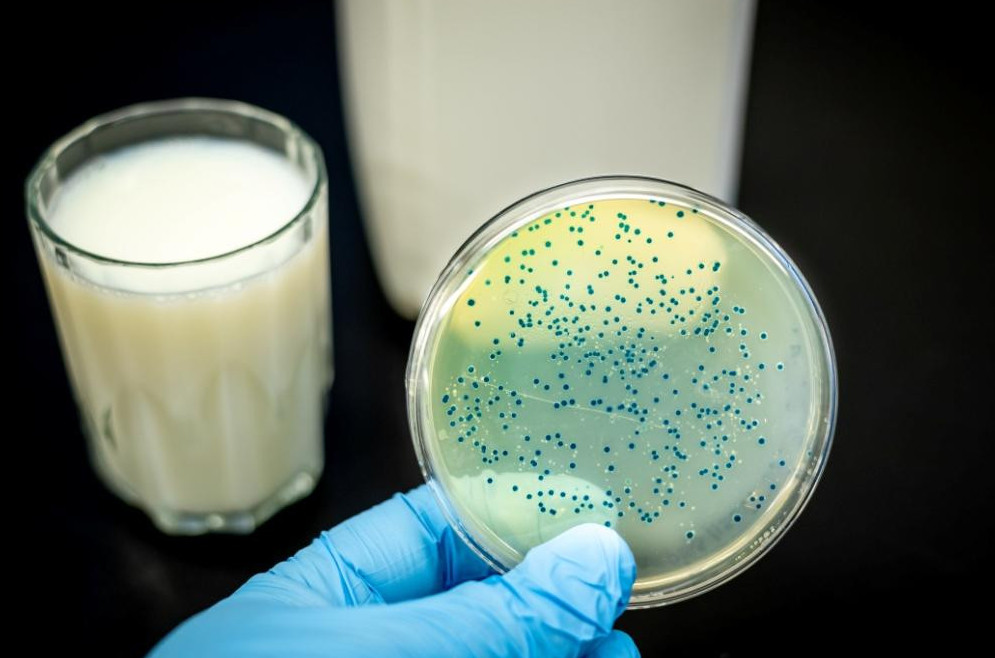
Қарағанды облысында 5 адам бруцеллез жұқтырды

Бруцеллезді жұқтыру жағдайларының 66,6%-ында тамаққа қайнатылмаған сүт және сүт өнімдерін пайдалану себеп болған.
Сондай-ақ дертке шалдыққандардың басым бөлігі сол сүт өнімдерін жеке тұлғалардан сатып алғанын айтады.
Ал қалған 33,3% жағдайда төрт түлікті асырау кезінде санитариялық-гигиеналық нормаларды бұзу, жануарларды уақтылы зертханалық тексеруден өткізбеуінен бруцеллез жұқтырған.
Бруцеллездің үй ошақтарынан алынған сынамаларда инфекция қоздырғыштары 7,8%-ында сүт өнімдерінен, 1,1%-ында тезектен, 2,2%-ында шөптен, 1,1%-ында жүннен анықталған.
Бұл зерттеу нәтижесі микробтардың қоршаған ортаға тарайтынын көрсетеді. Ол өз кезегінде инфекцияның таралу факторы болуы мүмкін.
«Биыл Шет, Бұқар жырау, Абай, Ақтоғай және Осакаров аудандарында адамдар үшін бруцеллез қоздырғышының негізгі көздері саналатын ірі қара және ұсақ мал арасында осы дерттің 391 жаңа эпизоотиялық ошағы анықталған», деп мәлімдеді Қарағанды облысының санитарлық-эпидемиологиялық департаменті.
Аяна Тоғанбек





































